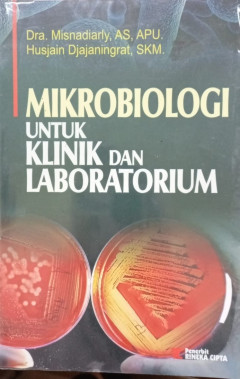
cover

Ditapis dengan
Mikrobiologi Pangan - Edisi Revisi -
Mikrobiologi pangan adalah cabang ilmu yang mempelajari tentang mikroorganisme (mikroba) yang hidup, tumbuh, atau mengontaminasi pangan
- Edisi
- Revisi
- ISBN/ISSN
- 978-623-256-878
- Deskripsi Fisik
- ix, 238 hlm : 23 cm
- Judul Seri
- -
- No. Panggil
- 664 WIN m

Mikrobiologi Pangan
Mikrobiologi pangan adalah cabang ilmu mikrobiologi yang mempelajari peran mikroorganisme (bakteri, fungi, virus, dll.) dalam makanan, baik yang menguntungkan maupun merugikan. Buku "Mikrobiologi Pangan" biasanya membahas interaksi mikroba dengan produk pangan, faktor-faktor yang mempengaruhinya, peran mikroba dalam fermentasi, serta metode pengendalian mikroba untuk menjaga kualitas dan keaman…
- Edisi
- -
- ISBN/ISSN
- 978-979-29-4542-3
- Deskripsi Fisik
- Abu/23:16/493 hlm
- Judul Seri
- -
- No. Panggil
- 663 TAT m

Mikrobiologi Klinik dan Parasitologi untuk Farmasi
Mikrobiologi klinik merupakan cabang ilmu kedokteran medis dengan kompetensi dari mikrobiologi kedokteran dan kedokteran umum untuk melakukan tindakan pengobatan dan pencegahan infeksi akibat mikroorganisme pada manusia juga lingkungan yang berkaitan dengan medis, seperti rumah sakit atau klinis.
- Edisi
- -
- ISBN/ISSN
- 978-602-376-684-0
- Deskripsi Fisik
- vi,177 hlm : ilus;22,8 cm
- Judul Seri
- -
- No. Panggil
- 616.96 TAT m

Mikrobiologi Pangan Edisi 5
Fundamental Food Microbiology, 5th Edition
- Edisi
- 5
- ISBN/ISSN
- 978-623-203-229-3
- Deskripsi Fisik
- xxxi, 404 hlm : ilus.; 24 x 15,5 cm; Hijau
- Judul Seri
- -
- No. Panggil
- 576.163 BIB m

Mikrobiologi Farmasi
Mikrobiologi dasar merupakan pelajaran bekal mahasiswa untuk memenuhi salah satu kegiatan akademik di fakultas farmasi
- Edisi
- -
- ISBN/ISSN
- 978-602-376-680-2
- Deskripsi Fisik
- vi, 202 hlm : ilus.; 23,2 x 15,2 cm; Putih
- Judul Seri
- -
- No. Panggil
- 616.01 TAT m

Mikrobiologi Untuk Klinik dan Laboratorium
penyakit infeksi yang di sebabkan oleh bakteri,fungsivirus,dan parasit sering di laporkan di indonesia
- Edisi
- -
- ISBN/ISSN
- 978-979-098-062-4
- Deskripsi Fisik
- Hitam/23.5:15.5/226
- Judul Seri
- -
- No. Panggil
- 616.01 MIS m

Mikrobiologi : menguak dunia mikroorganisme Jilid 2
Penelitian dalam bidang Mikrobiologi memerlukan keterampilan terutama dalam melakukan pemeriksaan di laboratorium
- Edisi
- Jilid 2
- ISBN/ISSN
- 979-543-460-8
- Deskripsi Fisik
- Hijau/24:15.5/304
- Judul Seri
- -
- No. Panggil
- 579 KOE m

Mikrobiologi
1. Pengantar mikrobiologi 2. Morfologi dan Anatomi Bakteri 3. Virus 4. Jamur (Fungi)
- Edisi
- -
- ISBN/ISSN
- 978-602-422-079-2
- Deskripsi Fisik
- Hijau/21:14/224
- Judul Seri
- -
- No. Panggil
- 610.96 MAD m
Mikrobiologi Farmasi : dasar-dasar mikrobiologi untuk mahasiswa farmasi
1. MIKROORGANISME 2. STRUKTUR SEL 3. KELOMPOK ORGANISME 4. GENETIKA MIKROORGANISME 5. PERTUMBUHAN MIKROORGANISME 6. METABOLIT MIKROORGANISME 7. STERILISASI 8. PATOGENESIS MIKROORGANISME 9. ANTIBIOTIK 10. PEMANFAATAN MIKROORGANISME SEBAGAI INDIKATOR UJI 11. KERUSAKAN PRODUK OBAT DAN MAKANAN SERTA PROSES PENCEGAHANNYA 12. MANFAAT MIKROORGANISME
- Edisi
- -
- ISBN/ISSN
- 978-602-376-253-8
- Deskripsi Fisik
- Putih/23;15/272
- Judul Seri
- -
- No. Panggil
- 616.01 DEW m
Mikrobiologi & Parasitologi Untuk Maha Siswa Farmasi
Buku ini diterbitkan guna memenuhi kebutuhan referensi materi mikrobiologi dan parasitologi dijenjang perguruan tinggi farmasi.
- Edisi
- -
- ISBN/ISSN
- 978-602-202-332-6
- Deskripsi Fisik
- -
- Judul Seri
- xiv,326 hlm : ilus;20,8 cm
- No. Panggil
- 616.01 TAT m
 Karya Umum
Karya Umum  Filsafat
Filsafat  Agama
Agama  Ilmu-ilmu Sosial
Ilmu-ilmu Sosial  Bahasa
Bahasa  Ilmu-ilmu Murni
Ilmu-ilmu Murni  Ilmu-ilmu Terapan
Ilmu-ilmu Terapan  Kesenian, Hiburan, dan Olahraga
Kesenian, Hiburan, dan Olahraga  Kesusastraan
Kesusastraan  Geografi dan Sejarah
Geografi dan Sejarah